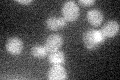
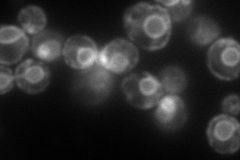
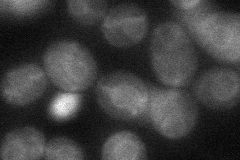
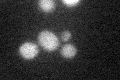

View description
Farnesyl-diphosphate farnesyl transferase (squalene synthase), joins two farnesyl pyrophosphate moieties to form squalene in the sterol biosynthesis pathway
Localization:
Intensity:
Fold change:
Significance:
-
C’ GFP library in SD
below threshold14.42 -
N' NOP1pr-GFP in SD
ER187.252 -
N' TEF2pr-mCherry in SD

ER384.615 -
N' NATIVEpr-GFP in SD

ER89.7665 -
N' TEF2pr-VC and Cyto-VN in SD
ER43.5016 -
C’ GFP library in SD+DTT
cytosol14.110.97No -
C’ GFP library in SD+H2O2

cytosol15.251.05No -
C’ GFP library in Starvation Media

cytosol17.811.23No -
C’ GFP library on the background of Pup2-DaMP

below threshold -
C’ GFP library on the background of CCT mutant

below threshold15.32221.06186No
